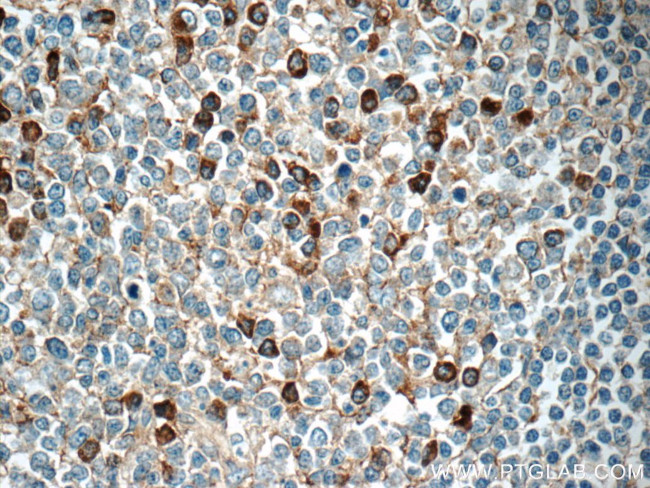
IGJ Antibody in Immunohistochemistry (Paraffin) (IHC (P))

Search
Proteintech
IGJ Polyclonal Antibody
{{$productOrderCtrl.translations['antibody.pdp.commerceCard.promotion.promotions']}}
{{$productOrderCtrl.translations['antibody.pdp.commerceCard.promotion.viewpromo']}}
{{$productOrderCtrl.translations['antibody.pdp.commerceCard.promotion.promocode']}}: {{promo.promoCode}} {{promo.promoTitle}} {{promo.promoDescription}}. {{$productOrderCtrl.translations['antibody.pdp.commerceCard.promotion.learnmore']}}
产品信息
13688-1-AP
种属反应
宿主/亚型
分类
类型
抗原
偶联物
形式
浓度
规格
纯化类型
保存液
内含物
保存条件
运输条件
产品详细信息
Immunogen sequence: MKNHLLFWG VLAVFIKAVH VKAQEDERIV LVDNKCKCAR ITSRIIRSSE DPNEDIVERN IRIIVPLNNR ENISDPTSPL RTRFVYHLSD LCKKCDPTEV ELDNQIVTAT QSNICDEDSA TETCYTYDRN KCYTAVVPLV YGGETKMVET ALTPDACYPD (1-159 aa encoded by BC038982)
靶标信息
J chain is a small glycopeptide and is structurally unrelated to heavy or light chains, but is synthesized by all plasma cells that secrete polymeric immunoglobulins. J chain is linked to IgA and IgM by disulfide bonds, however, it has been detected in IgG- and IgD-containing cells. J chains are present in a large proportion of the immunoglobulin-positive cells in the germinal centers of the tonsil and lymph node. B cells secrete J chain at an early stage of differentiation with the expression persisting in those cells destined to produce IgA or IgM.
仅用于科研。不用于诊断过程。未经明确授权不得转售。
生物信息学
蛋白别名: IgJ chain; Immunoglobulin J chain; immunoglobulin J polypeptide, linker protein for immunoglobulin alpha and mu polypeptides; immunoglobulin joining gene (not J region); J chain; Joining chain of multimeric IgA and IgM; unnamed protein product
基因别名: 9530090F24Rik; AI323815; IGCJ; IGJ; JCH; JCHAIN
UniProt ID: (Human) P01591, (Mouse) P01592
Entrez Gene ID: (Human) 3512, (Mouse) 16069